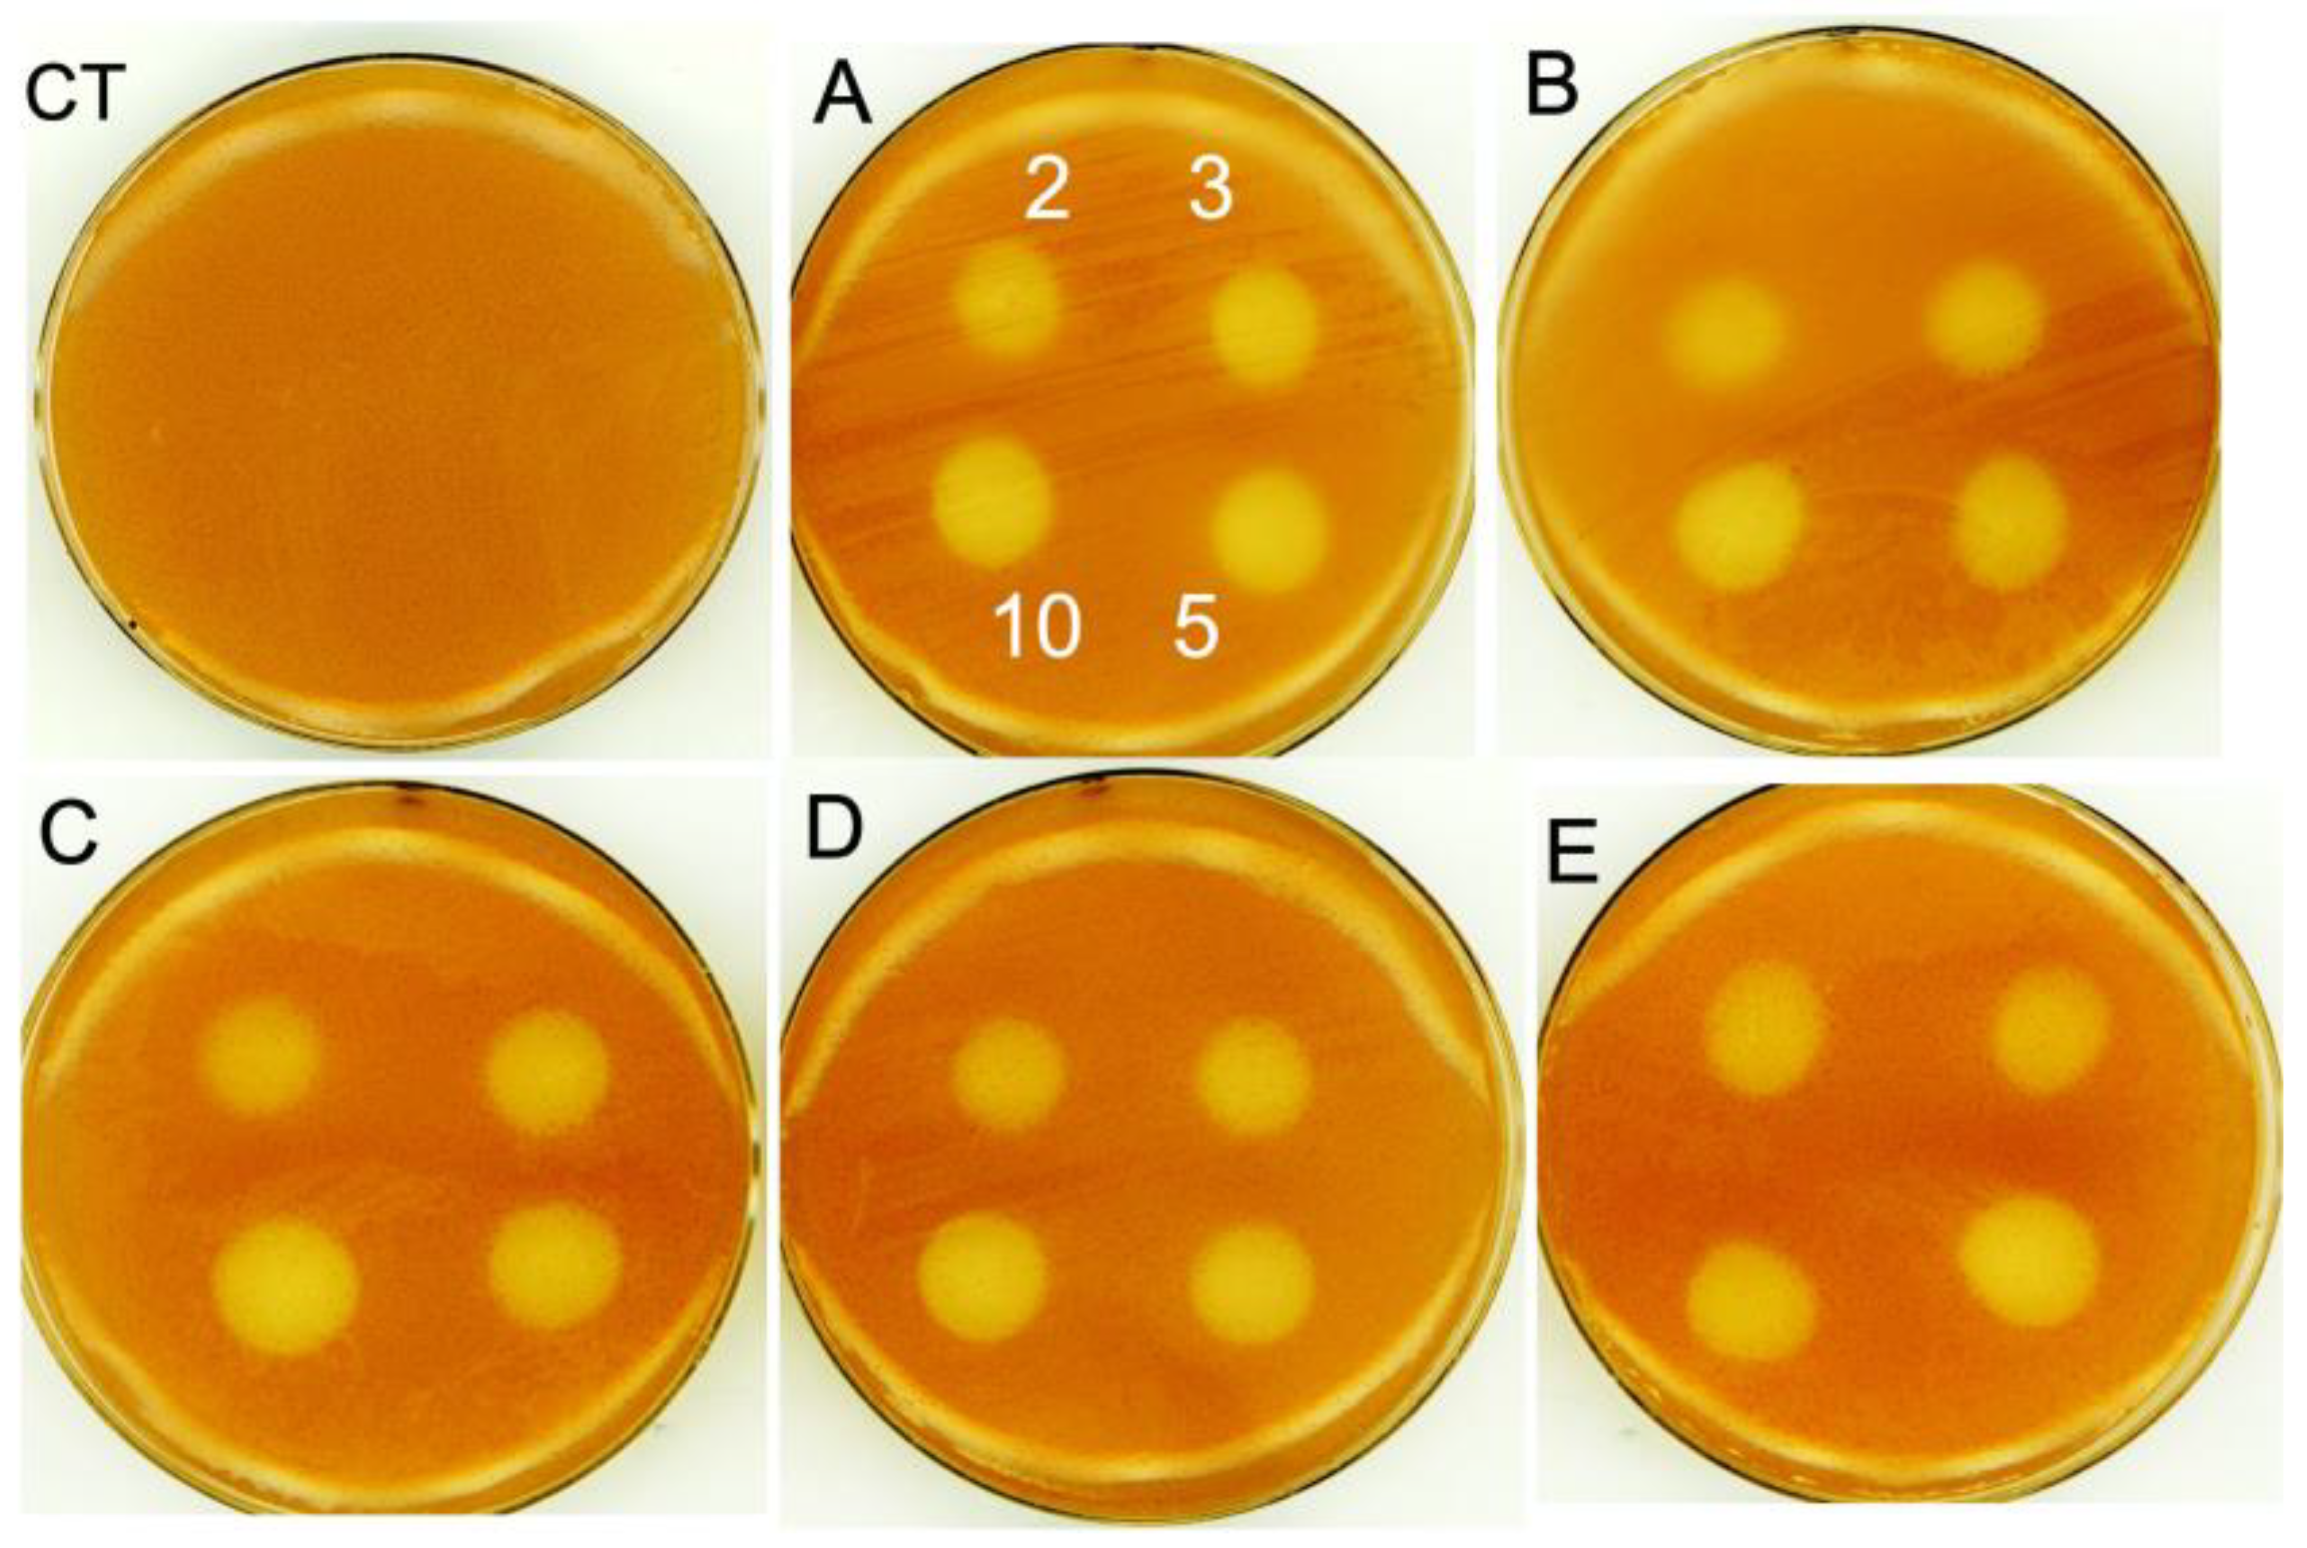
Nanomaterials 13 02788 g006

Adenosine-Monophosphate-Assisted Homogeneous Silica Coating of Silver Nanoparticles in High Yield
Abstract
:1. Introduction
2. Materials and Methods
2.1. Materials
2.2. Methods
2.2.1. Synthesis of AgNPs
2.2.2. Functionalization of AgNPs with AMP
2.2.3. Dense Silica Coating of AgNPs
2.2.4. Mesoporous Silica Coating of AgNPs
2.2.5. Bacterial Strains and Growth
2.2.6. Growth Inhibition Zone on Petri Dishes
2.2.7. Characterizations
2.2.8. ICP Analysis
3. Results and Discussion
3.1. Synthesis and Characterization of Nanoparticles
3.2. Antimicrobial Studies
4. Conclusions
Supplementary Materials
Author Contributions
Funding
Data Availability Statement
Acknowledgments
Conflicts of Interest
References
- Jouyban, A.; Rahimpour, E. Optical sensors based on silver nanoparticles for determination of pharmaceuticals: An overview of advances in the last decade. Talanta 2020, 217, 121071. [Google Scholar] [CrossRef]
- Li, D.; Yao, D.; Li, C.; Luo, Y.; Liang, A.; Wen, G.; Jiang, Z. Nanosol SERS quantitative analytical method: A review. TrAC-Trends Anal. Chem. 2020, 127, 115885. [Google Scholar] [CrossRef]
- Jeong, S.H.; Choi, H.; Kim, J.Y.; Lee, T.W. Silver-based nanoparticles for surface plasmon resonance in organic optoelectronics. Part. Part. Syst. Charact. 2015, 32, 164–175. [Google Scholar] [CrossRef]
- Bruna, T.; Maldonado-Bravo, F.; Jara, P.; Caro, N. Silver nanoparticles and their antibacterial applications. Int. J. Mol. Sci. 2021, 22, 7202. [Google Scholar] [CrossRef] [PubMed]
- Kowalczyk, P.; Szymczak, M.; Maciejewska, M.; Laskowski, Ł.; Laskowska, M.; Ostaszewski, R.; Skiba, G.; Franiak-Pietryga, I. All that glitters is not silver-A new look at microbiological and medical applications of silver nanoparticles. Int. J. Mol. Sci. 2021, 22, 854. [Google Scholar] [CrossRef] [PubMed]
- Guerrero-Martínez, A.; Pérez-Juste, J.; Liz-Marzán, L.M. Recent progress on silica coating of nanoparticles and related nanomaterials. Adv. Mater. 2010, 22, 1182–1195. [Google Scholar] [CrossRef] [PubMed]
- Liu, S.; Han, M.Y. Silica-coated metal nanoparticles. Chem. Asian J. 2010, 5, 36–45. [Google Scholar] [CrossRef]
- Ung, T.; Liz-Marzán, L.M.; Mulvaney, P. Controlled method for silica coating of silver colloids. Influence of coating on the rate of chemical reactions. Langmuir 1998, 14, 3740–3748. [Google Scholar] [CrossRef]
- Graf, C.; Vossen, D.L.J.; Imhof, A.; van Blaaderen, A. A General Method to Coat Colloidal Particles with Silica. Langmuir 2003, 19, 6693–6700. [Google Scholar] [CrossRef]
- Velikov, K.P.; Zegers, G.E.; van Blaaderen, A. Synthesis and Characterization of Large Colloidal Silver Particles. Langmuir 2003, 19, 1384–1389. [Google Scholar] [CrossRef]
- Hardikar, V.V.; Matijević, E. Coating of nanosize silver particles with silica. J. Colloid Interface Sci. 2000, 221, 133–136. [Google Scholar] [CrossRef]
- Niitsoo, O.; Couzis, A. Facile synthesis of silver core—Silica shell composite nanoparticles. J. Colloid Interface Sci. 2011, 354, 887–890. [Google Scholar] [CrossRef] [PubMed]
- Piotrowski, P.; Bukowska, J. Ion Permeation through Silica Coating of Silver Nanoparticles Functionalized with 2-Mercaptoethanesulfonate Anions: SiO2-Encapsulated SERS Probes for Metal Cations. J. Phys. Chem. C 2016, 120, 12092–12099. [Google Scholar] [CrossRef]
- Blake-Hedges, J.M.; Greenspan, S.H.; Kean, J.A.; McCarron, M.A.; Mendonca, M.L.; Wustholz, K.L. Plasmon-enhanced fluorescence of dyes on silica-coated silver nanoparticles: A single-nanoparticle spectroscopy study. Chem. Phys. Lett. 2015, 635, 328–333. [Google Scholar] [CrossRef]
- Kobayashi, Y.; Katakami, H.; Mine, E.; Nagao, D.; Konno, M.; Liz-Marzán, L.M. Silica coating of silver nanoparticles using a modified Stober method. J. Colloid Interface Sci. 2005, 283, 392–396. [Google Scholar] [CrossRef]
- Liu, S.; Zhang, Z.; Han, M. Gram-scale synthesis and biofunctionalization of silica-coated silver nanoparticles for fast colorimetric DNA detection. Anal. Chem. 2005, 77, 2595–2600. [Google Scholar] [CrossRef]
- Zhang, Y.; Li, X.; Xue, B.; Kong, X.; Liu, X.; Tu, L.; Chang, Y. A facile and general route to synthesize silica-coated SERS tags with the enhanced signal intensity. Sci. Rep. 2015, 5, 14934. [Google Scholar] [CrossRef]
- Kang, J.; Li, Y.; Chen, Y.; Wang, A.; Yue, B.; Qu, Y.; Zhao, Y.; Chu, H. Core-shell Ag@SiO2 nanoparticles of different silica shell thicknesses: Preparation and their effects on photoluminescence of lanthanide complexes. Mater. Res. Bull. 2015, 71, 116–121. [Google Scholar] [CrossRef]
- Lismont, M.; Páez, C.A.; Dreesen, L. A one-step short-time synthesis of Ag@SiO2 core-shell nanoparticles. J. Colloid Interface Sci. 2015, 447, 40–49. [Google Scholar] [CrossRef]
- Li, Z.; Jia, L.; Li, Y.; He, T.; Li, X.M. Ammonia-free preparation of Ag@SiO2 core/shell nanoparticles. Appl. Surf. Sci. 2015, 345, 122–126. [Google Scholar] [CrossRef]
- Han, L.; Wei, H.; Tu, B.; Zhao, D. A facile one-pot synthesis of uniform core-shell silver nanoparticle@mesoporous silica nanospheres. Chem. Commun. 2011, 47, 8536–8538. [Google Scholar] [CrossRef] [PubMed]
- Ertem, E.; Gutt, B.; Zuber, F.; Allegri, S.; Le Ouay, B.; Mefti, S.; Formentin, K.; Stellacci, F.; Ren, Q. Core-Shell Silver Nanoparticles in Endodontic Disinfection Solutions Enable Long-Term Antimicrobial Effect on Oral Biofilms. ACS Appl. Mater. Interfaces 2017, 9, 34762–34772. [Google Scholar] [CrossRef] [PubMed]
- Fathima, H.; Paul, L.; Thirunavukkuarasu, S.; Thomas, K.G. Mesoporous Silica-Capped Silver Nanoparticles for Sieving and Surface-Enhanced Raman Scattering-Based Sensing. ACS Appl. Nano Mater. 2020, 3, 6376–6384. [Google Scholar] [CrossRef]
- Saint-Cricq, P.; Wang, J.; Sugawara-Narutaki, A.; Shimojima, A.; Okubo, T. A new synthesis of well-dispersed, core-shell Ag@SiO2 mesoporous nanoparticles using amino acids and sugars. J. Mater. Chem. B 2013, 1, 2451–2454. [Google Scholar] [CrossRef]
- Wang, Y.; Ding, X.; Chen, Y.; Guo, M.; Zhang, Y.; Guo, X.; Gu, H. Antibiotic-loaded, silver core-embedded mesoporous silica nanovehicles as a synergistic antibacterial agent for the treatment of drug-resistant infections. Biomaterials 2016, 101, 207–216. [Google Scholar] [CrossRef] [PubMed]
- Fernández-Lodeiro, C.; Lodeiro, J.F.; Fernández-Lodeiro, A.; Nuti, S.; Lodeiro, C.; LaGrow, A.P.; Perez-Juste, I.; Perez-Juste, J.; Pastoriza-Santos, I. Synthesis of Tuneable Gold Nanostars: The Role of Adenosine Monophosphate. J. Mater. Chem. C 2023, 11, 12626–12636. [Google Scholar] [CrossRef]
- Djafari, J.; Fernández-Lodeiro, C.; Fernández-Lodeiro, A.; Silva, V.; Poeta, P.; Igrejas, G.; Lodeiro, C.; Capelo, J.L.; Fernández-Lodeiro, J. Exploring the control in antibacterial activity of silver triangular nanoplates by surface coating modulation. Front. Chem. 2019, 7, 677. [Google Scholar] [CrossRef] [PubMed]
- Fernández-Lodeiro, A.; Djafari, J.; Fernández-Lodeiro, J.; Duarte, M.P.; Mauricio, E.M.; Capelo-Martínez, J.L.; Lodeiro, C. Synthesis of mesoporous silica coated gold nanorods loaded with methylene blue and its potentials in antibacterial applications. Nanomaterials 2021, 11, 1338. [Google Scholar] [CrossRef]
- Chandra, R.; Kang, H. Mixed heavy metal stress on photosynthesis, transpiration rate, and chlorophyll content in poplar hybrids. Forest Sci. Technol. 2016, 12, 55–61. [Google Scholar] [CrossRef]
- Küpper, H.; Küpper, F.; Spiller, M. Environmental relevance of heavy metal-substituted chlorophylls using the example of water plants. J. Exp. Bot. 1996, 47, 259–266. [Google Scholar] [CrossRef]
- Lee, S.; Kim, Y.-Y.; Lee, Y.; An, G. Rice P1B-Type Heavy-Metal ATPase, OsHMA9, Is a Metal Efflux Protein. Plant Physiol. 2007, 145, 831–842. [Google Scholar] [CrossRef]
- Sabatini, S.E.; Juárez, Á.B.; Eppis, M.R.; Bianchi, L.; Luquet, C.M.; Ríos de Molina, M.d.C. Oxidative stress and antioxidant defenses in two green microalgae exposed to copper. Ecotoxicol. Environ. Saf. 2009, 72, 1200–1206. [Google Scholar] [CrossRef]
- Hassani, B.K.; Steunou, A.-S.; Liotenberg, S.; Reiss-Husson, F.; Astier, C.; Ouchane, S. Adaptation to Oxygen: Role of terminal oxidases in photosynthesis initiation in the purple photosynthetic bacterium, rubrivivax gelatinosus. J. Biol. Chem. 2010, 285, 19891–19899. [Google Scholar] [CrossRef] [PubMed]
- Nagashima, S.; Kamimura, A.; Shimizu, T.; Nakamura-Isaki, S.; Aono, E.; Sakamoto, K.; Ichikawa, N.; Nakazawa, H.; Sekine, M.; Yamazaki, S.; et al. Complete Genome Sequence of Phototrophic Betaproteobacterium Rubrivivax gelatinosus IL144. J. Bacteriol. 2012, 194, 3541–3542. [Google Scholar] [CrossRef]
- Curtis, P.D. Essential Genes Predicted in the Genome of Rubrivivax gelatinosus. J. Bacteriol. 2016, 198, 2244–2250. [Google Scholar] [CrossRef] [PubMed]
- Tambosi, R.; Liotenberg, S.; Bourbon, M.-L.; Steunou, A.-S.; Babot, M.; Durand, A.; Kebaili, N.; Ouchane, S. Silver and Copper Acute Effects on Membrane Proteins and Impact on Photosynthetic and Respiratory Complexes in Bacteria. mBio 2018, 9, 10-1128. [Google Scholar] [CrossRef]
- Bastús, N.G.; Merkoçi, F.; Piella, J.; Puntes, V. Synthesis of highly monodisperse citrate-stabilized silver nanoparticles of up to 200 nm: Kinetic control and catalytic properties. Chem. Mater. 2014, 26, 2836–2846. [Google Scholar] [CrossRef]
- Malay, O.; Yilgor, I.; Menceloglu, Y.Z. Effects of solvent on TEOS hydrolysis kinetics and silica particle size under basic conditions. J. Sol-Gel Sci. Technol. 2013, 67, 351–361. [Google Scholar] [CrossRef]
- Papadopoulou, E.; Bell, S.E.J. Surface-enhanced raman evidence of protonation, reorientation, and Ag+ complexation of deoxyadenosine and deoxyadenosine-5′- monophosphate (dAMP) on Ag and Au surfaces. J. Phys. Chem. C 2011, 115, 14228–14235. [Google Scholar] [CrossRef]
- Liz-Marzán, L.M.; Giersig, M.; Mulvaney, P. Synthesis of Nanosized Gold−Silica Core−Shell Particles. Langmuir 1996, 12, 4329–4335. [Google Scholar] [CrossRef]
- Rowe, L.R.; Chapman, B.S.; Tracy, J.B. Understanding and Controlling the Morphology of Silica Shells on Gold Nanorods. Chem. Mater. 2018, 30, 6249–6258. [Google Scholar] [CrossRef]
- Candreva, A.; Lewandowski, W.; La Deda, M. Thickness control of the silica shell: A way to tune the plasmonic properties of isolated and assembled gold nanorods. J. Nanopart. Res. 2021, 24, 19. [Google Scholar] [CrossRef]
- Abadeer, N.S.; Brennan, M.R.; Wilson, W.L.; Murphy, C.J. Distance and plasmon wavelength dependent fluorescence of molecules bound to silica-coated gold nanorods. ACS Nano 2014, 8, 8392–8406. [Google Scholar] [CrossRef] [PubMed]
- Li, D.; Li, H.; Fu, Y.; Zhang, J.L.; Li, W.; Han, Y.C.; Wang, L. Critical micelle concentrations of cetyltrimethylammonium chloride and their influence on the periodic structure of mesoporous silica. Colloid J. 2008, 70, 747–752. [Google Scholar] [CrossRef]
- Tofani, L.; Feis, A.; Snoke, R.E.; Berti, D.; Baglioni, P.; Smulevich, G. Spectroscopic and interfacial properties of myoglobin/surfactant complexes. Biophys. J. 2004, 87, 1186–1195. [Google Scholar] [CrossRef]
- Yoon, S.; Lee, B.; Kim, C.; Lee, J.H. Controlled Heterogeneous Nucleation for Synthesis of Uniform Mesoporous Silica-Coated Gold Nanorods with Tailorable Rotational Diffusion and 1 nm-Scale Size Tunability. Cryst. Growth Des. 2018, 18, 4731–4736. [Google Scholar] [CrossRef]
- Wu, C.; Xu, Q.H. Stable and functionable mesoporous silica-coated gold nanorods as sensitive localized surface plasmon resonance (LSPR) nanosensors. Langmuir 2009, 25, 9441–9446. [Google Scholar] [CrossRef]
- Morones, J.R.; Elechiguerra, J.L.; Camacho, A.; Holt, K.; Kouri, J.B.; Ramírez, J.T.; Yacaman, M.J. The bactericidal effect of silver nanoparticles. Nanotechnology 2005, 16, 2346–2353. [Google Scholar] [CrossRef]
- Xu, F.F.; Imlay, J.A. Silver(I), Mercury(II), Cadmium(II), and Zinc(II) Target Exposed Enzymic Iron-Sulfur Clusters when They Toxify Escherichia coli. Appl. Environ. Microbiol. 2012, 78, 3614–3621. [Google Scholar] [CrossRef]
- Panáček, A.; Kvítek, L.; Smékalová, M.; Večeřová, R.; Kolář, M.; Röderová, M.; Dyčka, F.; Šebela, M.; Prucek, R.; Tomanec, O.; et al. Bacterial resistance to silver nanoparticles and how to overcome it. Nat. Nanotechnol. 2018, 13, 65–71. [Google Scholar] [CrossRef]
- Tian, Y.; Qi, J.; Zhang, W.; Cai, Q.; Jiang, X. Facile, one-pot synthesis, and antibacterial activity of mesoporous silica nanoparticles decorated with well-dispersed silver nanoparticles. ACS Appl. Mater. Interfaces 2014, 6, 12038–12045. [Google Scholar] [CrossRef] [PubMed]
- Foerster, B.; Spata, V.A.; Carter, E.A.; Sönnichsen, C.; Link, S. Plasmon damping depends on the chemical nature of the nanoparticle interface. Sci. Adv. 2019, 5, eaav0704. [Google Scholar] [CrossRef] [PubMed]
- Dong, H.; Brennan, J.D. Rapid fabrication of core–shell silica particles using a multilayer-by-multilayer approach. Chem. Commun. 2011, 47, 1207–1209. [Google Scholar] [CrossRef] [PubMed]

| Sample | Identification | Size Core/Shell (nm) | Concentration (μg/mL) | |
|---|---|---|---|---|
| A | Ag@TA-SC | NPs | 28/- | 26.58 |
| B | Ag@AMP | NPs | 28/- | 50.02 |
| C | Ag@SiO2 | NPs | 28/10 | 63.36 |
| D | Ag@SiO2 | NPs | 28/16 | 54.12 |
| E | Ag@mSiO2 | NPs | 28/19 | 59.92 |
| Sample | Identification | Core Size/nm | Shell Thickness/nm | Type of Si |
|---|---|---|---|---|
| A | Ag@AT-SC NPs | 28.3 ± 2.6 | - | - |
| B | Ag@AMP NPs | 28.8 ± 2.5 | - | - |
| C | Ag@SiO2 NPs | 28.4 ± 2.8 | 9.3 ± 1.8 | Dense |
| D | Ag@SiO2 NPs | 28.5 ± 2.6 | 16.1 ± 2.8 | Dense |
| E | Ag@mSiO2 NPs | 28.9 ± 2.8 | 18.9 ± 1.9 | Mesoporous |
| AgNPs | MIC (µg/mL) | Interpretation in Solid Medium | MIC (µg/mL) | Interpretation in Solution Medium |
|---|---|---|---|---|
| A | <2 | Sensitive | ≤2 | Sensitive |
| B | <2 | Sensitive | <3 | Sensitive |
| C | <2 | Sensitive | <3 | Sensitive |
| D | <2 | Sensitive | <3 | Sensitive |
| E | <2 | Sensitive | <3 | Sensitive |
Disclaimer/Publisher’s Note: The statements, opinions and data contained in all publications are solely those of the individual author(s) and contributor(s) and not of MDPI and/or the editor(s). MDPI and/or the editor(s) disclaim responsibility for any injury to people or property resulting from any ideas, methods, instructions or products referred to in the content. |
© 2023 by the authors. Licensee MDPI, Basel, Switzerland. This article is an open access article distributed under the terms and conditions of the Creative Commons Attribution (CC BY) license (https://creativecommons.org/licenses/by/4.0/).
Share and Cite
Fernández-Lodeiro, C.; Tambosi, R.; Fernández-Lodeiro, J.; Fernández-Lodeiro, A.; Nuti, S.; Ouchane, S.; Kébaïli, N.; Pérez-Juste, J.; Pastoriza-Santos, I.; Lodeiro, C. Adenosine-Monophosphate-Assisted Homogeneous Silica Coating of Silver Nanoparticles in High Yield. Nanomaterials 2023, 13, 2788. https://doi.org/10.3390/nano13202788
Fernández-Lodeiro C, Tambosi R, Fernández-Lodeiro J, Fernández-Lodeiro A, Nuti S, Ouchane S, Kébaïli N, Pérez-Juste J, Pastoriza-Santos I, Lodeiro C. Adenosine-Monophosphate-Assisted Homogeneous Silica Coating of Silver Nanoparticles in High Yield. Nanomaterials. 2023; 13(20):2788. https://doi.org/10.3390/nano13202788
Chicago/Turabian StyleFernández-Lodeiro, Carlos, Reem Tambosi, Javier Fernández-Lodeiro, Adrián Fernández-Lodeiro, Silvia Nuti, Soufian Ouchane, Nouari Kébaïli, Jorge Pérez-Juste, Isabel Pastoriza-Santos, and Carlos Lodeiro. 2023. "Adenosine-Monophosphate-Assisted Homogeneous Silica Coating of Silver Nanoparticles in High Yield" Nanomaterials 13, no. 20: 2788. https://doi.org/10.3390/nano13202788
APA StyleFernández-Lodeiro, C., Tambosi, R., Fernández-Lodeiro, J., Fernández-Lodeiro, A., Nuti, S., Ouchane, S., Kébaïli, N., Pérez-Juste, J., Pastoriza-Santos, I., & Lodeiro, C. (2023). Adenosine-Monophosphate-Assisted Homogeneous Silica Coating of Silver Nanoparticles in High Yield. Nanomaterials, 13(20), 2788. https://doi.org/10.3390/nano13202788

